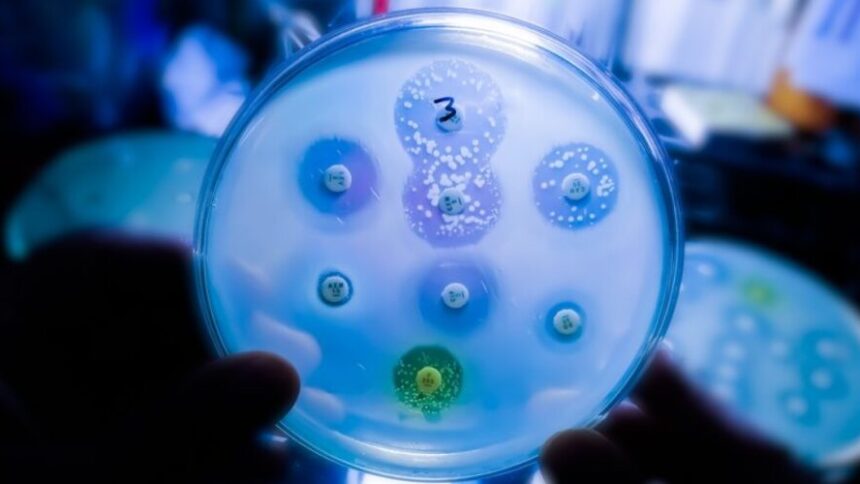

The dispute is growing over transferable vouchers for developers of novel antimicrobial products, proposed by the European Commission in the EU pharma package, but Prague is particularly concerned about the potential impact on national health systems.
Antimicrobial resistance (AMR) represents a challenge for the European healthcare system, claiming more than 35,000 lives every year.
The solution is new antimicrobials, whose development is time-consuming and costly.
The European Commission, therefore, wants to incentivise developers of novel antibiotics with special vouchers. These would grant them an additional year of regulatory data protection for one of their own products or those sold to another marketing authorisation holder.
However, the proposed voucher system has met resistance from member states and EU parliamentarians.
A letter from 14 countries – Netherlands, Austria, Belgium, Finland, France, Hungary, Ireland, Latvia, Lithuania, Luxembourg, Poland, Portugal, Slovakia, and Slovenia – opposing the proposal appeared last year. Czechia has joined the group, claiming the proposed voucher scheme was “non-transparent and unpredictable”.
“We do not know what kind of cost this will create for health insurance systems,” Deputy Health Minister Jakub Dvořáček explained to Euractiv.
The problem, he said, is that the innovation voucher can be transferred to another holder, so it is not clear which drug and which company it will go to. “It is motivating for the industry but opaque for the health insurance system,” Dvořáček warned.
“In general, the voucher system is not bad in itself, but we need to work out who bears the cost of it,” he added, saying that the proposal may mean that only some member states’ health systems will pay the cost of the voucher.
“Work is already underway to modify it, including at the working group level. A balanced approach needs to be found,” Dvořáček noted.
Draft report: Chapter deleted
Transferable AMR vouchers face criticism at the European Parliament’s ENVI committee, which is responsible for the pharma package.
“I am still not convinced of the transparency of the transferable exclusivity vouchers, and hence I deleted the chapter,” the rapporteur of the pharma regulation, Tiemo Wölken (S&D), told an ENVI committee debate on 7 November.
According to Wölken, the voucher system has a non-transparent impact on national health budgets and could also delay the entry of generic medicines into the market.
“Proposing such a measure without requirements and conditionality for a company to guarantee supply of the antimicrobial from which the voucher was awarded is inconceivable from my perspective,” the German MEP said.
As an alternative, Wölken proposed creating an EU scheme of incentives, which could include market entry rewards. Moreover, Wölken suggested the establishment of the European Medicines Facility, which would support research projects in AMR.
Criticism of the AMR voucher scheme is shared by the Czech MEP and shadow rapporteur of the file, Kateřina Konečná (the Left).
“I am not a huge fan of the transferable data exclusivity vouchers. They raise significant concerns. Consequently, I will support deleting this new tool,” Konečná told the ENVI committee meeting.
Cap on vouchers
On the other hand, the centre-right European People’s Party’s coordinator for the ENVI committee, Peter Liese, supported the voucher scheme. He called on his MEPs colleagues to continue working on vouchers as there is no better proposal on the table.
The Commission says the voucher scheme could address a potential market failure, as innovative antimicrobials could face a lack of interest from investors and developers.
As for its impact on national health systems, the Commission argues that costs will be counterbalanced by the prevented deaths and illnesses thanks to the novel antimicrobials.
The EU executive’s proposal also sets conditions for granting vouchers. Notably, only ten vouchers could be granted in 15 years – a measure that the Commission presented as a “cap” for the potential burden on national health systems.
[By Aneta Zachová | Edited by Vasiliki Angouridi/Zoran Radosavljevic]
Source: Euractiv.com

Leave a comment